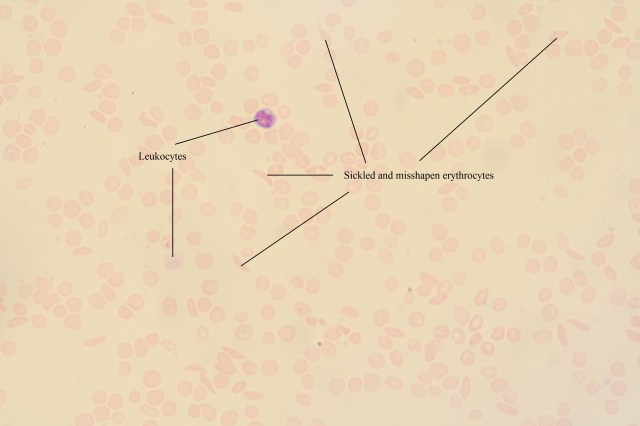
Sickle Cell Anaemia (labelled)
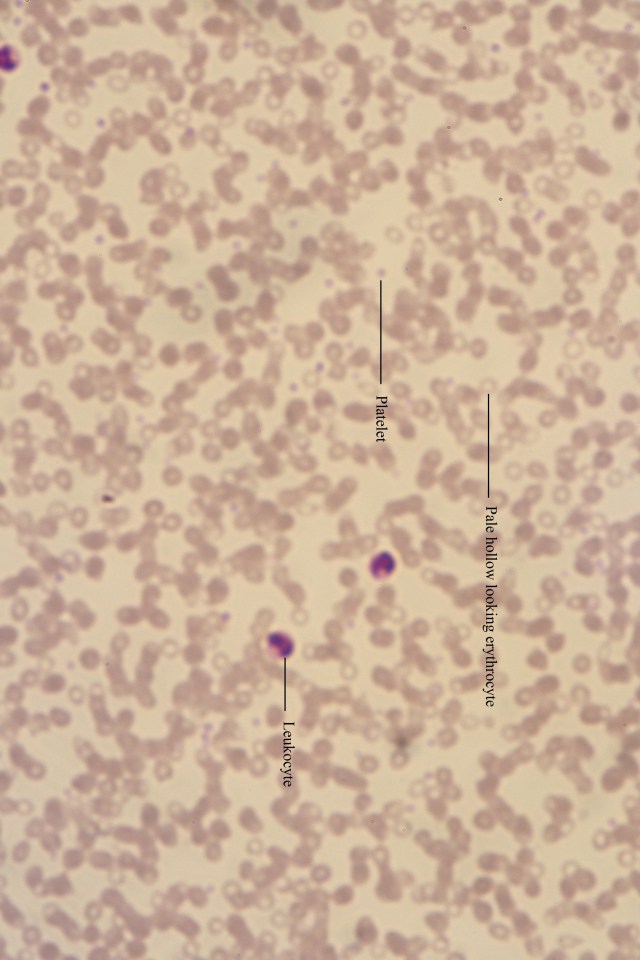
Cooleys anaemic blood (labelled)
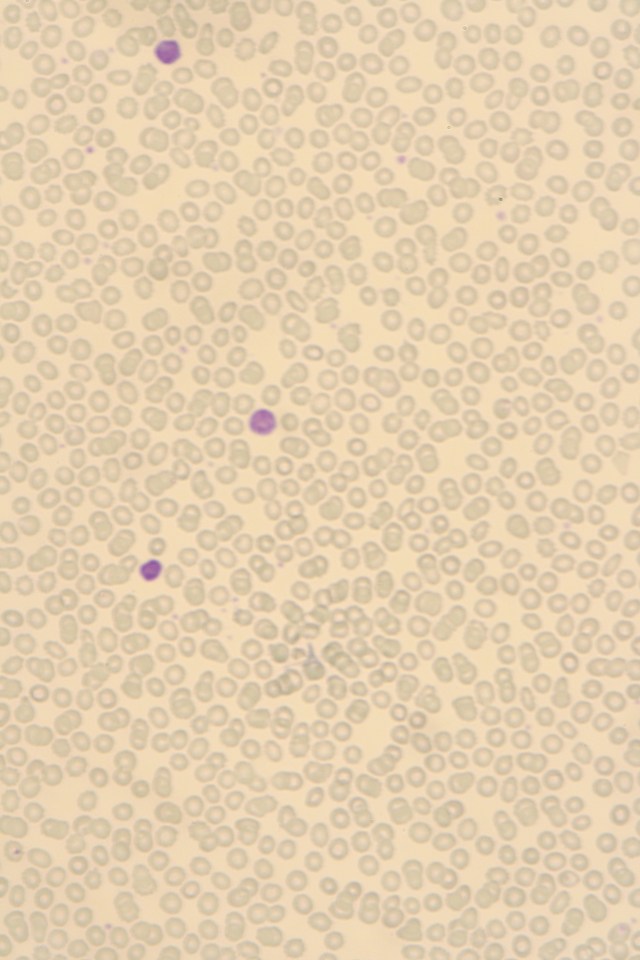
chronic lymphocytic leukemia
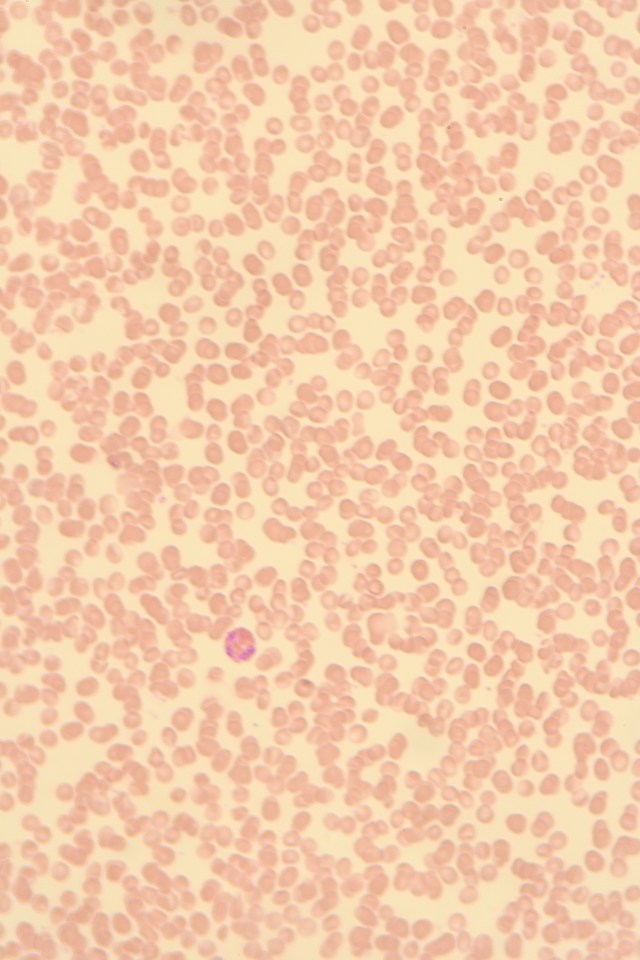
Blood smear with eosinophil
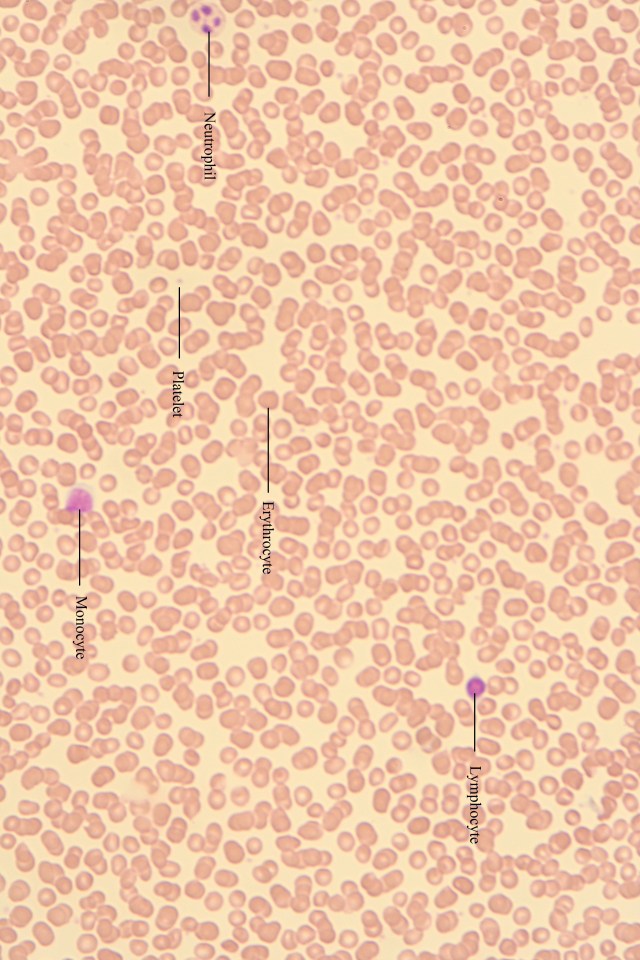
blood showing various cell types-1

Simple squamous epithelial tissue. Blood vessel lining.
Teased (separated) smooth muscle cells

Stratified squamous epithelial tissue (bottom) with connective tissue (top)
Skeletal muscle with striations

Spongy bone under red fluorescence

Skeletal muscle with striations
Simple squamous epithelium (layer at very top of tissue)

Simple ciliated columnar epithelium (upper respiratory tract, uterine ducts …)
Sickle cell anaemia red blood cell sample
Reticular tissue – network of support fibres for lymphatic system, found in lymph nodes, spleen, thymus and bone marrow.

Psuedo-stratified columnar epithelium (fluorescent).

Multipolar neurons (one axon, many dendrites)

Mammal motor nerve cells (yellow fluorescent imaging)

Intact smooth muscle.

Hyaline cartilage

Human adipose tissue

Fibrous (dense) connective tissue tissue – notice the wavy pattern of the collagen. Tendons and ligaments.

Elastic tissue – found on the wall of the aorta, for example, to provide recoil. Also found in other arteries and in the lungs.

Elastic cartilage – contains elastic fibres instead of collagen. Found in external ear, auditory tubes and the larynx.

Cuboidal epithelium – single layer of cells. Found lining nephrons of the kidneys. Also found in glandular ducts, ovaries, thyroid gland and repiratory bronchioles.

Cooleys (Thalassemia) anaemic blood. Note the clear blood cells. A genetic disorder, the body makes an abnormal form of hemoglobin.
Compact bone


Ciliated columnar epithelium

Chronic lymphocytic leukemia
Cardiac muscle

Cancellous (spongy) bone

Brown adipose tissue – each cell contains small lipid droplets and a high number of iron containing mitochondria. Generates heat by burning calories. Newborns do not shiver with cold because they have their brown adipose tissue levels are higher than adults.

Blood smear with eosinophil
Blood showing various cell types
Areolar tissue (loose connective tissue with collagen and fibroblasts)
